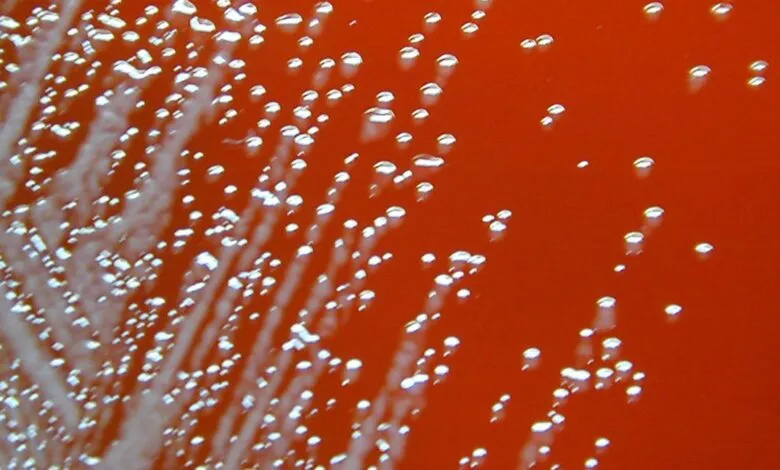
Microscopic view of bacterial colonies on an orange agar plate, showing white colonies and gas bubbles.

Mysterious ’80s Deaths Linked to Recent Fatal Illnesses
▼ Summary
– Four men in the same Georgia county were infected with a rare tropical soil bacterium, Burkholderia pseudomallei, with genetic analysis showing a shared source.
– None of the men had recent travel to endemic regions, and infections occurred decades apart, with cases in 1983, 1989, and two in September 2024.
– Researchers concluded the bacterium has been present in the Georgia soil for decades, based on the linked cases and lack of alternative explanations.
– Hurricane Helene is suggested as the trigger for the recent infections, as severe weather events are known to increase exposure in endemic areas.
– The two 2024 patients worked outdoors during the hurricane at the same site, facing mud, rain, and wind, and fell ill shortly after exposure.
A cluster of mysterious infections in Georgia has revealed a decades-long presence of a dangerous tropical bacterium in local soil, with recent cases potentially linked to extreme weather events. Four men from the same county were infected by Burkholderia pseudomallei, a pathogen typically found in regions like Southeast Asia and northern Australia. Despite the geographic and temporal spread of the cases, occurring in 1983, 1989, and two more just a day apart in September 2024, genetic analysis confirmed the bacterial strains were closely related, pointing to a persistent local source rather than travel-related exposure.
None of the individuals had recently visited endemic areas, and only one had a history of travel to such regions, decades before falling ill. This unusual pattern led researchers to conclude the bacterium has been present in the local environment for over forty years. A study published in Emerging Infectious Diseases suggests that Hurricane Helene may have played a key role in reactivating the dormant pathogen. The storm brought severe conditions to Georgia on September 26, including heavy rain, strong winds, and widespread soil disruption.
The two most recent patients both worked outdoors during the hurricane, at the same site, where they were exposed to mud, dust, and flooding. One man, in his 50s, became ill on September 28 after inspecting vehicles in the storm conditions. Another, in his 60s, operated heavy equipment and developed symptoms the following day. These cases align with known patterns in endemic regions, where melioidosis infections often surge after extreme weather, as disturbed soil and contaminated water increase human exposure to the bacteria.
(Source: Ars Technica)